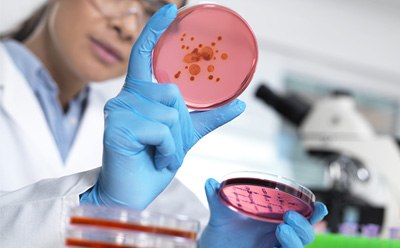
女性科学家正在检查培养基内的微生物培养物。

生物负荷检测
生物负荷指的是灭菌前物体表面(或整个物体)、设备内部或部分液体中所存在的活微生物。生产过程中使用的原材料、生产环境中的工作人员或者在成品包装过程中,均有可能引入生物负荷。 由于潜在污染源众多,产品的生物负荷会存在批次间差异,因此应实施常规检测以控制质量。
推荐类别
生物负荷检测的基本原则
生物负荷检测或微生物检测是一种质量控制工艺,可检测和量化产品在生产的不同阶段(例如从启动生产到最后配送)中的微生物污染情况。为最大限度降低消费者风险、满足生产环境的监管要求,必须保证有效的质量控制和准确的检测结果。因此,生物负荷检测通常被纳入常规检测,以确保每批次产品的安全性、质量和监管合规。
医疗器械、药品、食品和饮料、水、包装材料、原材料、人体组织、动物组织和化妆品均可进行生物负荷检测。在遵循以下标准方法时,重要的是要确保检测方法不会将微生物引入待测样品或者杀灭待测样品中的微生物。
膜过滤法生物负荷检测
膜过滤是检测含抗菌物质的产品的首选方法。在此方法中,样品流经一个孔径为0.45 µm的膜过滤器。滤膜形成一道屏障,截获大于滤膜孔径的微生物。在过滤的过程中,可使用真空来加快工艺速度。随后将滤膜转移至培养基上,放入培养箱中至少孵育5天:细菌检测温度30–35 °C,真菌检测温度20–25 °C。对所得培养物进行计数,确定样品微生物污染水平。应采取适当措施,以避免可能的交叉污染导致假阳性结果。
直接铺板法生物负荷检测
直接铺板法生物负荷检测包括倒平板法和涂平板法。倒平板法因理论准确度更高而更受欢迎。在倒平板法中,需将灭菌 培养基 加入含待检样品的培养皿中,等待固化。涂平板法要求将样品加入含无菌固化培养基的培养皿中。无论采取上述哪一方法,在样品加入培养体系中后,均须孵育平板并对所得的培养物计数。
最大可能数(MPN)法生物负荷检测
最大可能数(MPN)法是一种定量方法,用于测定微生物在样品中的近似浓度。此方法要求将原始溶液或样品按数量级(通常为10x或2x)分装至培养液中,进而评估是否存在微生物。MPN法的缺点在于,须在适当稀释度下大量重复进行以缩小置信区间。此外,该方法仅可有效检验微生物有无,无法提供可靠的菌落计数结果。
相关文章
- Detect microbial contamination faster with the Milliflex® Quantum system. Using fluorescence-based technology, this non-destructive method can help microbiological enumeration before the colonies become visible
- Comparison of convenience, operating time, accuracy, costs and safety aspects of single-use funnels vs. reusable funnels for the membrane filtration method in QC microbiology.
- S-Pak® membrane filters for microbial bioburden testing
- Compatibility of Microcon® PES filter devices with sodium hydroxide treatment for cleaning and sanitization.
- Selective media enable faster results and visual confirmation for the detection, identification, and enumeration of microorganisms
- 查看完整内容 (10)
相关实验方案
- Routine water and beverage microbiological analysis using the 55-Plus™ Monitor
- MicropreSure® on-line filtration system for in-process microbiology testing
- General protocols for growth of competent cells in microbial medium.
查找更多文章和实验方案
我们可以提供哪些帮助
如有任何疑问,请提交客户支持请求
或联系我们的客户服务团队:
发送电子邮件至 custserv@sial.com
或致电 +1 (800) 244-1173
更多支持
- Chromatogram Search
Use the Chromatogram Search to identify unknown compounds in your sample.
- 计算器与应用_缓冲液计算器_HPLC方法转换计算器-默克生命科学
默克该工具箱包括用于化学、生命科学、材料科学等方面的科学研究工具和资源。
- Customer Support Request
Customer support including help with orders, products, accounts, and website technical issues.
- FAQ
Explore our Frequently Asked Questions for answers to commonly asked questions about our products and services.
如要继续阅读,请登录或创建帐户。
暂无帐户?


